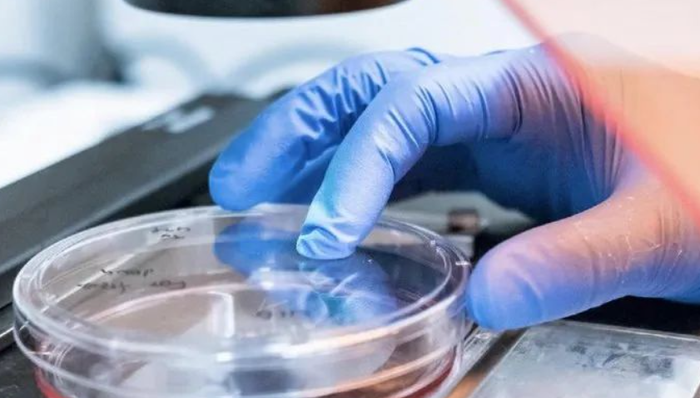
3D模型,化妝品研發(fā),實驗,

文|聚美麗 小栗子
近年來,越發(fā)理智的消費者對化妝品的關(guān)注不再停留在“成分”,而是逐漸升級為對產(chǎn)品“功效評價”的重視,國家關(guān)于化妝品的法規(guī)要求中也逐漸重視產(chǎn)品多方位的功效評價。這些都促使各品牌以更嚴謹?shù)膽B(tài)度對待產(chǎn)品開發(fā),為產(chǎn)品出具功效評價報告。
在化妝品安全性和功效性評價中,動物實驗是進行人體試驗前的重要一環(huán)。
但近年來,研發(fā)過程中不采取動物實驗的“零殘忍”理念在國外深入人心,在國內(nèi)也逐漸獲得認可。2013年起,歐盟就全面禁止對化妝品產(chǎn)品和成分進行動物實驗,澳大利亞、新西蘭、印度等國也相繼發(fā)布相關(guān)法令,我國國內(nèi)也在逐步放寬對動物實驗的要求。
尋找動物實驗的替代方法成為化妝品行業(yè)的迫切需要,3D皮膚模型因此頻繁地出現(xiàn)在功效評價報告中,不少人認為其有望代替動物模型進行化妝品的安全性和功效性評價。
那么,3D皮膚模型究竟是什么,在功效性評價中能提供哪方面依據(jù),現(xiàn)階段又有哪些前沿進展?本文就以上幾點進行簡要闡述。

模擬人體真實皮膚,從“表皮”到“全層”
在解釋3D皮膚模型前,我們需要先清楚人體的皮膚結(jié)構(gòu)。人體皮膚可分為3層:表皮、真皮及皮下組織。各層含有的具體結(jié)構(gòu)和細胞組成請參照以下結(jié)構(gòu)圖和思維導圖:

圖:人體皮膚結(jié)構(gòu)

而3D皮膚模型就是以人體皮膚細胞為材料、在體外構(gòu)建出的、模擬人體真實皮膚三維結(jié)構(gòu)的活性組織。
目前構(gòu)建3D皮膚模型的方法主要有兩種:組織工程技術(shù)和3D生物打印技術(shù)。組織工程技術(shù)本質(zhì)上是用角質(zhì)形成細胞和成纖維細胞在支架上進行培養(yǎng),搭建表皮和真皮的模型,是一種體外培養(yǎng)細胞的方式。
3D生物打印技術(shù)則是以細胞、生物墨水為原材料,在生物打印儀器上進行模型打印,進一步后續(xù)培養(yǎng)的技術(shù)(下文“3D生物打???逐漸接近‘真實’”一欄中將詳細介紹)。
國內(nèi)常見的3D皮膚模型可分為3種:表皮模型、黑素皮膚模型、全層皮膚模型。
3D表皮模型
顧名思義,3D表皮模型模擬的是人體皮膚的表皮。自1979年首例含有功能性表皮層的皮膚模型構(gòu)建以來,已經(jīng)有多款皮膚模型在體外構(gòu)建成功:其中包括法國的EpiSkin、SkinEthic RHE,美國的EpiDerm,德國的epiCS,日本的LabCyte EPI - MODEL,以及中國EpiKutis 和EpiSkin 。
其中EpiKutis 是由中國人皮膚組織分離出的角質(zhì)形成細胞,在特定的培養(yǎng)環(huán)境下生成的活性組織(屬于組織工程技術(shù))。它與正常人體表皮高度類似,是具有典型的基底層、棘層、顆粒層及角質(zhì)層的表皮復層化結(jié)構(gòu)。

圖:EpiKutis 表皮模型,圖源博溪生物官網(wǎng)
EpiKutis 是目前國內(nèi)首款實現(xiàn)產(chǎn)業(yè)化生產(chǎn)的皮膚測試模型,也是皮膚生物學研究和化妝品體外功效性評價的一個有效工具。
3D黑素皮膚模型
3D黑素皮膚模型則是在表皮模型的基礎(chǔ)上,含有5%~10%不等比例黑素細胞的組織,目前在體外構(gòu)建成功的模型有法國的SkinEthic RHPE、美國的MelanoDerm、德國的epiCS-M以及中國的MelaKutis 等。

圖:MelaKutis 黑素皮膚模型,圖源博溪生物官網(wǎng)
其中,據(jù)博溪生物官網(wǎng)顯示,MelaKutis 具有高度類似于天然皮膚的黑素顆粒分布,其黑素細胞在體外能正常合成黑素,且能模擬受試物作用于人體皮膚后黑素細胞與表皮其他細胞的相互作用,對外界黑素細胞刺激因子如紫外光線(UV)、霧霾等具有應(yīng)答反應(yīng)。
3D全層皮膚模型
3D全層皮膚模型除了含表皮層外,還包括成纖維細胞構(gòu)建的真皮層,基本模擬了人體皮膚的“全層”。
利用組織工程技術(shù)構(gòu)建全層模型的過程通常如下:將活體的成纖維細胞在支架上培養(yǎng)形成真皮結(jié)構(gòu),再進一步與角質(zhì)形成細胞進行復合培養(yǎng)形成全層結(jié)構(gòu)。和人體皮膚一致的是,全層皮膚模型具備充分的真皮-表皮細胞相互作用。
目前已有多款3D全層皮膚模型在體外構(gòu)建成功:其中包括法國的T-Skin、美國的EpiDerm FT、德國的Phenion FT以及中國的FulKutis 。

圖:FulKutis 全層皮膚模型,圖源博溪生物官網(wǎng)
現(xiàn)在,國內(nèi)參與全層皮膚模型研究的企業(yè)較多,如伽藍、貝泰妮、至本等均有一定研究。
其中,伽藍在2017年申請了“一種3D全層皮膚模型及用于其形成的培養(yǎng)基、制備方法”的專利。此前,在2014年,伽藍就啟動了“3D皮膚細胞模型”項目,與法國皮膚實驗室合作,成功用3D生物打印機打印出亞洲人的皮膚。
除上述三種模型外,在皮膚醫(yī)學的研究過程中也會用到一些疾病型的皮膚模型,如痤瘡、菌類感染皮膚模型。
如何應(yīng)用于功效評價?
根據(jù)2021年藥監(jiān)局發(fā)布的《化妝品功效宣稱評價規(guī)范》,初步判斷,采用3D皮膚模型進行的功效評價屬于實驗室試驗一類——體外試驗中組織層面的評價。
(注:《化妝品功效宣稱評價規(guī)范》將化妝品功效評價宣稱試驗分為人體功效評價試驗、消費者使用測試和實驗室試驗3類。其中,實驗室試驗包括但不限于動物試驗、體外試驗(包括離體器官、組織、細胞、微生物、理化試驗)等。)

圖:截自《化妝品功效宣稱評價規(guī)范》
一般來說,不同種類的3D皮膚模型適用的功效評價也不同。表皮模型通常用于評價皮膚屏障修護、保濕、UV防護、經(jīng)皮吸收情況等,黑素皮膚模型用于評價美白效果,而全層皮膚模型則用于評價抗衰、皮膚含水量變化等相關(guān)功效。
3D表皮模型——屏障修護、安全性
上文提到,表皮模型模擬的是人體皮膚表皮,表皮中的角質(zhì)層與皮膚屏障息息相關(guān),故在進行屏障修護功效評價時可用該模型。
有研究顯示,在化妝品屏障增強功效評價實驗中,利用免疫熒光技術(shù)對不同處理條件下的 3D表皮模型EpiKutis 進行蛋白水平分析。與對照組相比,樣品處理后,F(xiàn)LG與LOR均顯著升高,證明樣品具有同時促進FLG,LOR表達,提升皮膚屏障的功能。
(注:FLG是一種與皮膚屏障相關(guān)的蛋白,含量高反映皮膚屏障功能較好;LOR占角質(zhì)層總蛋白的大部分,能加固角質(zhì)層。)

圖:FLG、LOR免疫熒光實驗結(jié)果圖,截自參考文獻[2]
功效性物質(zhì)發(fā)揮作用需要滲透進入活組織,故該模型與人體皮膚相似的皮膚屏障功能也可為經(jīng)皮吸收研究提供有效工具。
除功效性評價之外,3D表皮模型更多被用于評價化妝品安全性,在這方面已有較為成熟的評價方法。
經(jīng)濟合作與發(fā)展組織(OECD)發(fā)布過體外皮膚組織模型的三個關(guān)鍵OECD測試指南,包括:a、皮膚腐蝕 (OECD TG 431);b、皮膚刺激 (OECD TG 439);c、皮膚敏化(OECD TG 442D),為皮膚模型的安全性評價提供了實踐指南。
3D黑素皮膚模型——美白
基底層的黑素細胞產(chǎn)生的黑素是皮膚變黑、出現(xiàn)色斑的的“元兇”,故含有黑素細胞的3D黑素皮膚模型通常用于美白產(chǎn)品多維度的功效評價。
測試時可以將受試物直接涂抹于皮膚模型表面,UV照射培養(yǎng)后,觀察相對于對照組模型的顏色和亮度變化,或定量檢測表皮中黑素含量、酪氨酸酶活性和黑素合成及轉(zhuǎn)運相關(guān)基因的表達情況。
博溪生物總經(jīng)理盧永波在一次演講中,曾展示過雅詩蘭黛專研光透煥白精華素的美白功效評價案例:在戶外紫外線(UVB)的照射下,涂抹該產(chǎn)品后的實驗組,直觀上色度明顯比對照組要淡一些,其他的量化指標也能證明其美白效果。

圖:雅詩蘭黛專研光透煥白精華素的美白功效檢測案例
并且他提到,3D黑素皮膚模型通過呈現(xiàn)組織的黑素分布形態(tài),可以清晰地看出該產(chǎn)品的原理是抑制黑素合成,或是抑制黑素轉(zhuǎn)運,同時也可獲悉產(chǎn)品的溫和性情況。
3D全層皮膚模型——抗衰
與皮膚老化密切相關(guān)的膠原蛋白位于真皮層,具有祛皺效果的透明質(zhì)酸,其生理位置處于真皮層基質(zhì),故在評價產(chǎn)品抗衰功效時可采用包含真皮層的3D全層皮膚模型。有研究表明,一些蛋白質(zhì)指標可以作為評價中的標志物,以量化測試結(jié)果。
隨著皮膚老化,真皮與表皮的連接減弱、成纖維細胞數(shù)量減少、以及合成一些重要蛋白的能力減弱——如膠原蛋白、彈性蛋白和蛋白聚糖的含量發(fā)生變化,這些蛋白質(zhì)的含量在一定程度上能反映皮膚強度、皮膚彈性、真皮含水量,從而指示皮膚的衰老情況。
伽藍集團曾用3D全層皮膚模型對喜馬拉雅雪松精粹和喜默因做過功效評價試驗。
比如,在研究雪松精粹對皮膚真皮-表皮連接處(DEJ)的作用時,結(jié)果顯示該活性物可以明顯提高表皮的厚度,增加皮膚抵抗外界環(huán)境的屏障能力,并且在全層皮膚模型上可以直觀地看到:其能顯著促進DEJ重要蛋白層粘連蛋白5(Laminin 5)和VII型膠原蛋白(Collagen VII,Col VII)的表達。

圖:Laminin 5、Col VII免疫熒光染色結(jié)果,截自參考文獻[6]
(注:DEJ具有緊致表皮,進行真皮-表皮間物質(zhì)交換的作用。研究表明,DEJ 的健康與否,直接影響皮膚的整體狀態(tài),維持健康的DEJ是預防衰老的關(guān)鍵;Laminin 5和Col VII是DEJ內(nèi)的重要蛋白,兩者表達量的增加能穩(wěn)固DEJ結(jié)構(gòu)。)
還有華熙生物也做過以全層模型上蛋白質(zhì)含量變化,以顯示產(chǎn)品功效的評價實驗。
另外,有國外研究顯示,全層皮膚模型可用于評估新原料引起的DNA損傷(遺傳毒性)情況,在化妝品的安全性評價上具有一定意義。
從以上功效評價的例子中可以看出,比起細胞和單純組織的體外試驗,3D皮膚模型可以整合基因水平、蛋白水平與組織水平的多維度數(shù)據(jù)。
此外,有學者表示,傳統(tǒng)功效評價采用的動物模型與人類在生理功能、組織結(jié)構(gòu)、代謝途徑以及遺傳應(yīng)答等方面具有種間差異,實驗結(jié)果外推到人類時具有不確定性。而人體臨床評價對評估者的經(jīng)驗有一定要求,且成本較高。這2種方法的評價周期較長、重復性差、精確度低。
而3D皮膚模型相對來講,試驗周期短、實驗條件可控且結(jié)果易于定量,故其在功效評價中的運用受到越來越多化妝品企業(yè)的重視。
3D生物打???逐漸接近“真實”
隨著需求的提升和科研的持續(xù)深入,3D皮膚模型的發(fā)展在不斷貼近人體天然皮膚結(jié)構(gòu)的同時,生產(chǎn)方式上也持續(xù)更新,以提高模型的精度和可重復性。
3D生物打印——高精度、可重復、可定制
上文提到,構(gòu)建體外皮膚模型的方式有組織工程技術(shù)和3D生物打印技術(shù)。率先發(fā)展的組織工程技術(shù)由于對細胞和材料的沉積控制有限,故構(gòu)建出的皮膚模型不能完全概括天然皮膚的結(jié)構(gòu)。
而3D生物打印能夠使用計算機輔助設(shè)計(CAD)預先定義活細胞、生物材料和生長因子的沉積,從而通過具有高精度和可重復的逐層打印過程制造可定制的結(jié)構(gòu),仿生性更強。
3D打印皮膚的制造過程可分為四步:a、前處理:包括皮膚細胞選擇、生物材料選擇和模型設(shè)計;b、實際打印過程;c、后處理:包括3D打印皮膚細胞的增殖、組織的形成和成熟;d、3D打印皮膚的評價:包括皮膚組織的生化和生理特征。

圖:3D打印皮膚的制造過程,圖源藥大妝妍
目前,3D打印的皮膚模型在國外處于“蓬勃發(fā)展”發(fā)展階段,不少生物科技公司推出了商業(yè)化的皮膚模型。
2020年11月,法國初創(chuàng)公司CTIBiotech推出了兩種用于皮膚護理的生物打印全皮膚模型。該公司通過改進生物打印專業(yè)知識,以生產(chǎn)出適用于皮膚護理應(yīng)用的新模型,可滿足不斷反復地測試需求,以評估皮膚美容產(chǎn)品中所含成分的功效和安全性。
巴斯夫和拜爾斯道夫是最早使用該公司模型的企業(yè),現(xiàn)在CTIBiotech也正在為更多的企業(yè)和巴黎的臨床醫(yī)院測試生物打印模型。CTIBiotech還與其他企業(yè)一起開發(fā)了含皮脂細胞的皮膚模型。
另外,北京深藍云生物科技有限公司售有CELLINK BIOX 3D生物打印儀器,該儀器的打印原材料為:GelXA Skin生物墨水、Col MA生物墨水;人真皮成纖維細胞、表皮角質(zhì)形成細胞。儀器能實現(xiàn)全厚度皮膚組織模型的3D生物打印。

圖:CELLINK BIOX 3D生物打印儀器,圖源深藍云生物科技公眾號
有血管或神經(jīng)組織的皮膚模型
生產(chǎn)技術(shù)的進步為3D皮膚模型的發(fā)展提供了更為廣闊的空間,一些專家已經(jīng)構(gòu)建出具有血管或神經(jīng)組織的皮膚模型。
韓國浦項科技大學機械工程學院Byoung Soo Kim等研究人員,在自行設(shè)計的多功能生物3D打印平臺上,利用噴墨和擠出打印兩種工藝構(gòu)建了包含表皮、真皮和皮下組織的體外全層皮膚模型,在該模型真皮層和皮下組織的交界處含有內(nèi)皮化且可灌注的血管。
該模型經(jīng)大分子滲透實驗證明:打印后內(nèi)皮化的血管具有選擇滲透性,具有實際血管的特定功能。
并且,在多種混合培養(yǎng)液的共同作用下,通過細胞功能表達標志物的檢測,證明了與只含有表皮層和真皮層的皮膚模型相比,血管化的全層皮膚組織模型具有與實際皮膚更接近的復雜結(jié)構(gòu)和完整功能,其細胞功能標記物的表達更為充分。

圖:含血管通道的全層皮膚模型,圖源3D打印分會中國機械工程學會
除此之外,巴斯夫利用一家法國初創(chuàng)公司NETRI的創(chuàng)新技術(shù),在芯片上搭建了受神經(jīng)支配的衰老皮膚模型。(詳情請點擊:歐詩漫新推珍珠美白成分/巴斯夫開發(fā)“神經(jīng)皮膚芯片”丨原料新品10)
與傳統(tǒng)通過共培養(yǎng)得到的皮膚模型(上述組織工程建立的皮膚模型屬于這一類)相比,該技術(shù)更準確地模擬了皮膚內(nèi)部的神經(jīng)生理機制。
Gattefossé與生物力學和高分辨率生物學成像專家BioMeca也聯(lián)合開發(fā)了一種不含任何外源性基質(zhì)的3D真皮微組織模型。
雖然在3D皮膚模型上開展化妝品功效評價已經(jīng)成為行業(yè)發(fā)展的趨勢之一,但有學者表示,商業(yè)化皮膚模型仍存在一些不足之處:成熟應(yīng)用的大部分皮膚模型缺乏毛囊、汗腺和皮脂腺等皮膚附屬結(jié)構(gòu);作為單一的組織模型,無法測試組織和其他器官、生物系統(tǒng)的相互作用;
在有效檢測長時間多次的日常使用功效上,有待進一步發(fā)展;皮膚屏障功能弱于真人皮膚,受試物的經(jīng)皮吸收率較高;皮膚模型的供應(yīng)商有限,價格較高;不同種子細胞來源的皮膚模型(指構(gòu)建皮膚模型的原細胞來自不同部位)在測量指標上存在差異等。
有專家認為,基于3D皮膚模型的評價結(jié)果能在多大功能范圍,多大程度上代表人群的功效反應(yīng),是人們共同關(guān)注的問題。這個問題也直接影響了化妝品功效性體外檢測方法的系統(tǒng)設(shè)計與實施。
一些專家也指出了皮膚模型的未來發(fā)展方向,“皮膚模型未來的發(fā)展應(yīng)包括進一步積累各種功效原料的多維度實驗數(shù)據(jù),整合并提高與人體臨床數(shù)據(jù)的科學相關(guān)性和預測性,以及研究如何延長皮膚模型的培養(yǎng)時間,從而進行化妝品日常使用功效的評價等?!?/p>
3D皮膚模型確實為化妝品功效評價提供了科學依據(jù),但也僅是體外功效試驗的一種,要對化妝品功效進行全面評價仍要結(jié)合多維度的數(shù)據(jù)。
“我們需要整合多維度數(shù)據(jù)來綜合評價體外科學檢測的功效數(shù)據(jù),需要實現(xiàn)多維度的科學邏輯統(tǒng)一,才能達到更好的化妝品功效評價結(jié)果?!币粚<以诰C述中表示。
參考文獻:
[1]宋肖潔, 周春霞, 吳越. 3D皮膚模型的構(gòu)建及其在化妝品原料活性物功效檢測中的應(yīng)用研究[J]. 日用化學工業(yè), 2017, 47(11):5.
[2]李瀟, 張曉娥, 盧永波,等. 化妝品功效評價(Ⅷ)——3D皮膚模型在化妝品功效評價中的應(yīng)用[J]. 日用化學工業(yè), 2018, 48(9):7.
[3]盧永波, 李瀟, 張艷云,等. 基于3D皮膚模型的安全性及功效性研究[C]// 2015毒性測試替代方法與轉(zhuǎn)化毒理學(國際)學術(shù)研討會.
[4]張春曉, 杜鎮(zhèn)建, Zhi Wang,等. 3D-人造皮膚模型在化妝品安全性,功效性評價中的應(yīng)用[J]. 北京日化, 2014(2):3.
[5]孔雪,趙華,唐穎.皮膚模型在化妝品功效評價中的應(yīng)用研究進展[J]. 日用化學工業(yè), 2017,47(4):228-231,236.
[6]宋肖潔, 周春霞, 吳越. 3D皮膚模型的構(gòu)建及其在化妝品原料活性物功效檢測中的應(yīng)用研究[J]. 日用化學工業(yè), 2017, 47(11):5.
信息來源:百度百科,premium BEAUTY news,《化妝品功效宣稱評價規(guī)范》,博溪生物官網(wǎng),公眾號:藥大妝妍 、南極熊3D打印、3D打印分會中國機械工程學會、深藍云生物科技